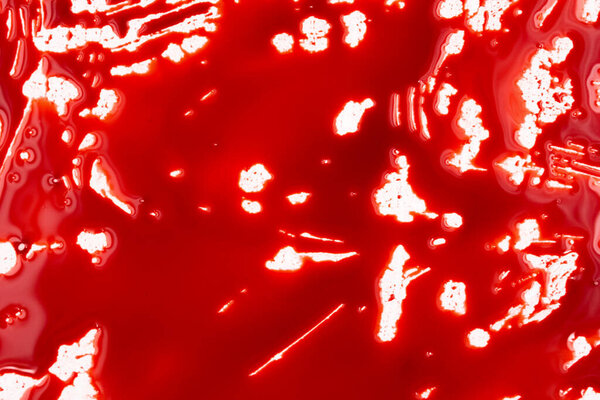
Bloody splashes and drops on a white background. Dripping and following red blood (paint)

- /
- Search /
- Female Menstruation bleeding
Female Menstruation bleeding
Female Menstruation bleeding. 3d illustration
image
image
Jun.22, 2016 10:42:16
8.29
0.56
281x500
563x1000
1125x2000
2160x3840
2160x3840
379
13
sciencepics
RED BACKGROUND ILLUSTRATION HUMAN FEMALE HEALTH BLOOD MEDICINE MEDICAL 3D WOMAN DISEASE PROBLEM CYCLE SYSTEM FIBER FERTILITY ANATOMY NORMAL REPRODUCTION FERTILE PREGNANCY PERIOD BLEEDING UTERUS GYNECOLOGY HORMONE MENSTRUATION REPRODUCTIVE MENOPAUSE HYPERPLASIA ENDOMETRIUM UTERINE ENDOMETRIAL ENDOMETRIOSIS